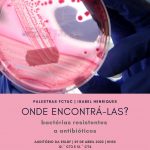

- Posted on
- Editor LR
Atividades SBE 2021-2022
Agora que chegámos ao final do ano letivo, apresentamos uma síntese das atividades desenvolvidas pelos Serviços das Bibliotecas Escolares do AELdF e que implicaram a participação direta dos alunos.
Atividades de promoção do livro e da leitura, representações teatrais, palestras e concursos foram as atividades mais dinamizadas, em articulação com os Departamentos Curriculares, a Equipa PES e a Rede de Bibliotecas de Cantanhede. Atividades que envolveram crianças e alunos, desde os Jardins de Infância ao 12.º ano.
Visitas à página (Total): 1147 - Visitas à página (Hoje): 1